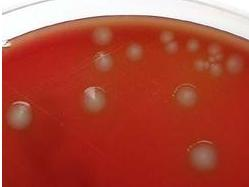

出血败血性巴斯德菌感染
概述
Pasleurella菌是一种小的、革兰染色阴性的杆菌,广泛存在于家养和野生动物的呼吸道和肠道内,当宿主的抵抗力下降时,即可发病。正常情况下,人体内无该菌存在,大多数病人都在被猫、狗和其他动物抓伤、咬伤后发病,引起以累及皮肤为主的疾病。皮损与咬伤的范围、深度有关,初起伤口周围红肿,迅速扩大破溃,从一个或多个窦道内排出灰黄色血性脓液,部分病例伤口边缘明显触痛,如伤口深,可引起骨膜炎、滑膜炎。依据病史,实验室分离出生长缓慢、革兰染色阴性杆菌可确诊。对青霉素、氨苄西林(氨苄青霉素)和四环素敏感。
发病原因
症状
 好发于手,臂部和下肢,皮损与咬伤的范围,深度有关,初起伤口周围红肿,迅速扩大破溃,从一个或多个窦道内排出灰黄色血性脓液,部分病例伤口边缘明显触痛,如伤口深,可引起骨膜炎,滑膜炎,约有15%的病人,发病前无被动物咬伤史,但有腹部,肺部创口等病史。
好发于手,臂部和下肢,皮损与咬伤的范围,深度有关,初起伤口周围红肿,迅速扩大破溃,从一个或多个窦道内排出灰黄色血性脓液,部分病例伤口边缘明显触痛,如伤口深,可引起骨膜炎,滑膜炎,约有15%的病人,发病前无被动物咬伤史,但有腹部,肺部创口等病史。
检查
分离出生长缓慢,革兰染色阴性杆菌有助诊断。
并发症
并发肺脓肿、肺气肿及败血症。败血症是一种血液中毒的病症。患者多是免疫系统比较差的人,主因则是身体某些部位的细菌扩散至血液,细菌在血液中大量繁殖并且产生毒素,令人体器官功能受损,并会在病发时衰竭。但是,有一部份的败血症患者仍然找不到原发病灶。
治疗
对青霉素、氨苄西林(氨苄青霉素)和四环素敏感。由于目前常见致病菌对四环素类耐药现象严重,仅在病原菌对本品呈现敏感时,方有指征选用该类药物。由于溶血性链球菌多对本品呈现耐药,不宜选用于该类菌所致感染的治疗。本品亦不宜用于治疗溶血性链球菌感染和任何类型的葡萄球菌感染。
预防
加强劳动保护。对生产过程中的有害气体、粉尘、如矽尘、氯氨、溴、碘等需要妥善处理,长期与有害化学气体接触的工作人员,应配戴防毒面具与穿防护隔离衣等。禁烟禁酒:是预防咽喉癌的首要措施烟为辛热之魁,酒为湿热之最,吸烟、喝酒对咽部的危害极大。
饮食保健
附件列表
词条内容仅供参考,如果您需要解决具体问题
(尤其在法律、医学等领域),建议您咨询相关领域专业人士。
Pasleurella菌是一种小的,革兰染色阴性的杆菌,广泛存在于家养和野生动物的呼吸道和肠道
Pasleurella菌是一种小的,革兰染色阴性的杆菌,广泛存在于家养和野生动物的呼吸道和肠道